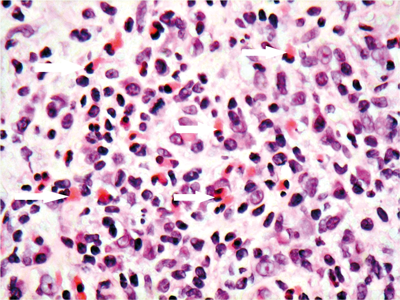

History
-
A 16-year-old female presents with bilateral ocular irritation. The patient has a history of seasonal rhinitis and eczema and complains of itchy eyes, especially during the summer months.
-
Examination shows bilateral mucoid discharge, conjunctival injection and eversion of both upper lids reveals some dome-shaped lesions. One of these is biopsied and shown in Figures 1, 2 and 3. The eyelid skin is not involved.
-
Figure 1 is a low power of one of the tarsal based nodules. Figure 2 shows the surface of the nodule. Figure 3 shows the stroma of the nodule.

Figure 1.
Figure 2.
Figure 3.
Questions
-
In Figure 2, name the epithelium type that covers the nodule.
-
In Figure 2 what is the other cell type you can see in the epithelium?
-
In Figure 3, which cell is indicated by the white arrows?
-
What is the clinico-pathologic differential diagnosis?
-
What are the clinical complications of this condition?
Answers
1. Non keratinising, stratified squamous epithelium.
2. Goblet cells, which in this case are excessive in number (hypertrophy and hyperplastic). The increased goblet cells numbers lead to the excessive mucus discharge.
3. These are eosinophils, with distinctive bright pink cytoplasm. Eosinophils release cytokines that are involved in triggering the itch cycle, as observed clinically.
4. The differential diagnosis is between allergic keratoconjunctivitis (AKC) and vernal keratoconjunctivitis (VKC).The favoured interpretation is VKC as the eyelid skin was not involved. What was seen clinically were macropapillae / cobblestones.
5. Punctate epithelial erosions, corneal macroerosions, shield ulcers and plaques, psuedogerentoxon, corneal peripheral superficial vascularisation.
COMMENTS ARE WELCOME

